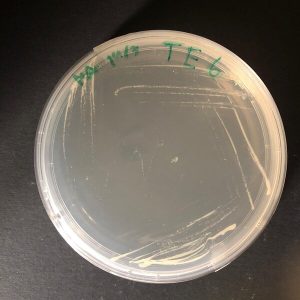

Send us an expression of interest by e-mail (ccmarcts@ualg.pt / ccmarassemble@ualg.pt).
For order confirmation, the User shall read the Terms of Use and complete and sign an Order Form and a Material Transfer Agreement.
Instructions for payment will be sent after receiving the request.

-
Warning: Undefined variable $attachment_image in /home/ccmarbio/public_html/wp-content/themes/flacio/inc/woocommerce.php on line 353

Sulfitobacter sp.
CCMAR-S_SA14
-
Warning: Undefined variable $attachment_image in /home/ccmarbio/public_html/wp-content/themes/flacio/inc/woocommerce.php on line 353

Tenacibaculum soleae
CCMAR-S_PC47
-
Warning: Undefined variable $attachment_image in /home/ccmarbio/public_html/wp-content/themes/flacio/inc/woocommerce.php on line 353

Cobetia marina
CCMAR-S_PG74
-
Warning: Undefined variable $attachment_image in /home/ccmarbio/public_html/wp-content/themes/flacio/inc/woocommerce.php on line 353

Arthrobacter aurescens
CCMAR-S_DR21
-
Warning: Undefined variable $attachment_image in /home/ccmarbio/public_html/wp-content/themes/flacio/inc/woocommerce.php on line 353

Pseudoalteromonas marina
CCMAR-S_DR21
-
Arthrobacter aurescens
CCMAR-S_DR21
-
Warning: Undefined variable $attachment_image in /home/ccmarbio/public_html/wp-content/themes/flacio/inc/woocommerce.php on line 353
Cobetia sp.
CCMAR-S_PGTE6
-
Warning: Undefined variable $attachment_image in /home/ccmarbio/public_html/wp-content/themes/flacio/inc/woocommerce.php on line 353

Laminaria ochroleuca
CCMAR-P_LO1_RO
-
Warning: Undefined variable $attachment_image in /home/ccmarbio/public_html/wp-content/themes/flacio/inc/woocommerce.php on line 353

Ulva australis
CCMAR-S_UL9_FF
-
Warning: Undefined variable $attachment_image in /home/ccmarbio/public_html/wp-content/themes/flacio/inc/woocommerce.php on line 353

Ulva compressa
CCMAR-S_UC5_FF
-
Warning: Undefined variable $attachment_image in /home/ccmarbio/public_html/wp-content/themes/flacio/inc/woocommerce.php on line 353

Grateloupia turuturu
CCMAR-S_GG1_FF
-
Warning: Undefined variable $attachment_image in /home/ccmarbio/public_html/wp-content/themes/flacio/inc/woocommerce.php on line 353

Phyllariopsis purpurascens
CCMAR-S_PP3.2U_AF


